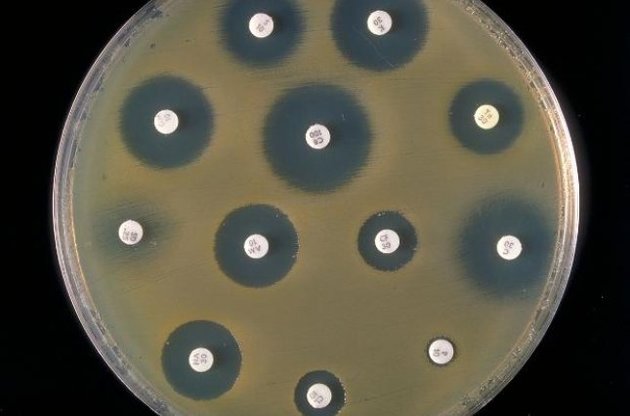
Чистые области вокруг антибиотиков демонстрируют их эффективность

Ученые из Вермонтского университета пришли к выводу, что отдельные клетки в бактериальных колониях способны спонтанно увеличивать устойчивость к антибиотикам на непродолжительное время. Работа была опубликована в журнале Scientific Reports.
Бактерии становятся устойчивым к антибиотикам благодаря мутациям, которые происходят в них. Бактерии, которые обладают этими мутациями, передают их своим потомкам или другим бактериям благодаря горизонтальному переносу генов. Таким образом, количество бактерий, устойчивых к антибиотикам, стремительно возрастает.
Ученые выяснили, что устойчивость к антибиотикам может возрастать и без мутаций в генах. Исследовав культуры E. coli, подвергавшиеся воздействию антибиотика карбенициллина, микробиологи выяснили, что в колониях бактерий некоторые микроорганизмы время от времени способны увеличивать свою резистентность. Причиной явления, называемого временной устойчивостью, оказались случайные процессы, происходящие внутри клеток.
Исследователи продемонстрировали, что среди бактериальных клеток наблюдаются колебания активности белка MarA - фактора множественной устойчивости к антибиотикам, который приводит к активации генов, отвечающих за невосприимчивость микроорганизма к антибактериальным препаратам. Это позволяет некоторым клеткам выживать при летальных дозах антибиотиков и восстанавливать всю популяцию.
По мнению исследователей, обнаруженный феномен позволит сделать методы лечения антибиотиками более эффективными.
Ранее сообщалось о том, что бактерии приобрели устойчивость к антибиотикам "последней надежды". Это означает, что в скором времени возможно появление бактерий, стойких ко всем известным типам лекарств, и такие гены стойкости уже замечены у бактерий, которые поражают людей.